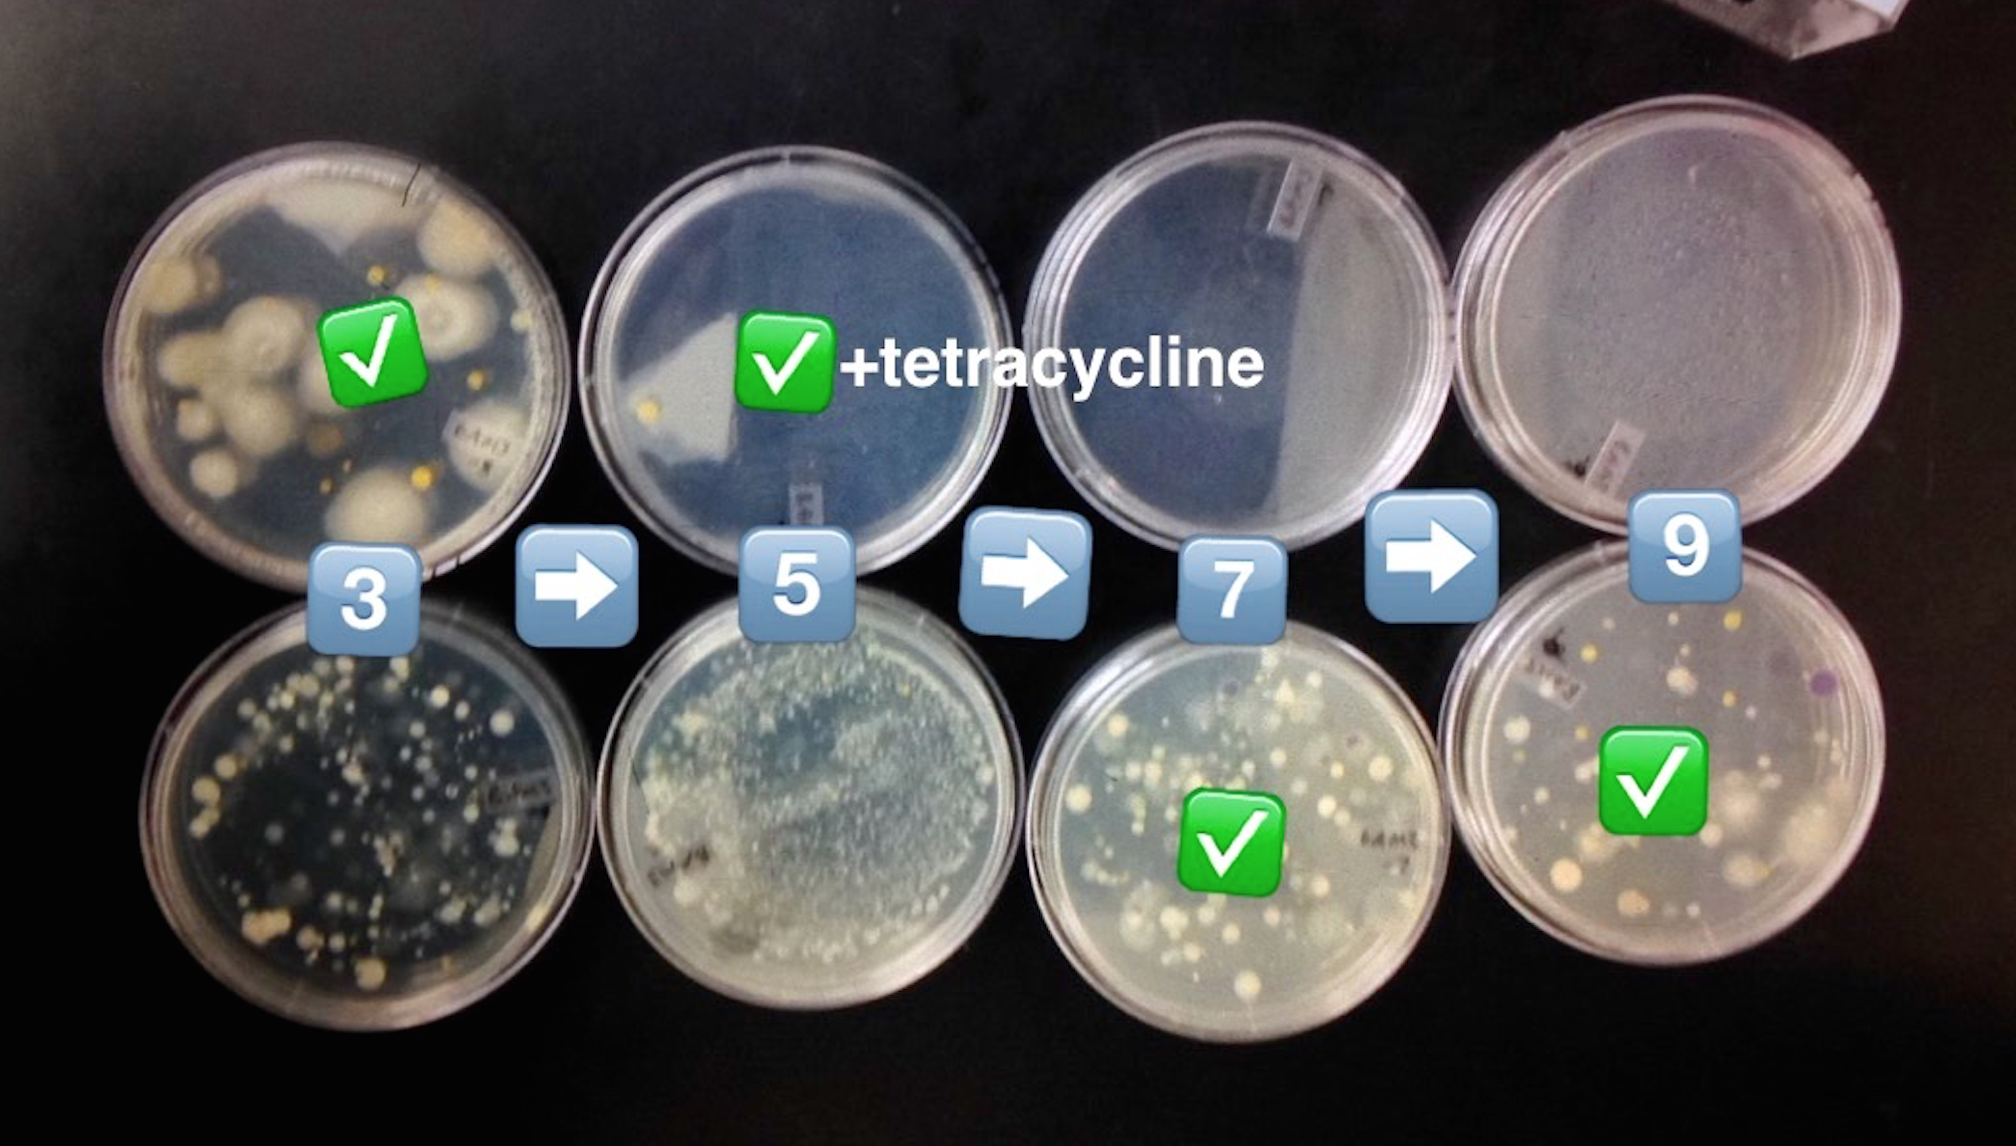

User:Student 67/Notebook/Biology 210 at AU
Thursday, March 3, 2016
Zebrafish
Purpose:
The purpose of this experiment was to observe the impact of continuous movement and physiological stress on the embryological development of zebrafish. It was hypothesized that the constant motion the experimental group was exposed to would lead to irregular growth, anxious behavior, and overall physical stress that would eventually lead to the fish dying prematurely.
Materials & Methods:
The experiment began with a total of 48 zebrafish eggs. Of these fish, 24 were put into a controlled apparatus, while the other 24 served as the experimental group upon which we would expose to the variables set forth. The experimental group of fish were exposed to 200 RPM (revolutions per minute) on a Hybrid Capture System machine 24/7 for the entirety of the 14 day duration of the experiment. Each zebrafish was kept in its own 1-in diameter well that was filled with a solution of bottled water and methylene blue to prevent fungal growth. The zebrafish were observed every few days to clean the water and feed them and in order to observe and determine whether or not the continuous motion and stress had an effect on their development.
Figure 1: Stages of Embryonic Development of Zebrafish
Table 1: Data Collection for Control Zebrafish
Table 2: Data Collection for Experimental Zebrafish
Tables 1 & 2: These tables show the qualitative observations of the Zebrafish during development from egg to the larval stage. Those that indicate "motile" were seen to be actively swimming about during observation. Those noted as "nonmotile" were seen to be sedentary, yet with mild agitation of the apparatus, did in fact move around. Control fish on average survived until Day 14, while Experimental fish did not survive past day 11 of observation.
Conclusions:
By the conclusion of the experiment, every last zebrafish had died. The experimental group that was exposed to the physical stress of the constant motion succumbed significantly sooner than the control group. On average, the control group lived 3 days longer than the experimental group. It was observed that the experimental group actually seemed to develop faster than the control group. When examining their deceased bodies, it was seen that the experimental fish actually had a slight growth curvature as opposed to the controls that grew straight. This would suggest that the physical stress the experimental fish were exposed to actually made them develop too fast, almost to the point where their bodies could not handle it. However, the differences in movement in the experimental and control groups were not very different from one another over the duration of the experiment. More studies on other types of physical stress on zebra fish would help in learning about their effects on zebrafish development.
AP
Thursday, February 25, 2016
16S Sequence Analysis
The purpose of the following experiment was to use primers and PCR (polymerase chain reaction) to amplify the 16S rRNA gene in one of the two nutrient agar plates with and without tetracycline. The hypothesis was that the gene sequence found would be a resilient specimen to have survived growing on a +tet plate. Also, the bacteria would have been a commonly occurring specimen in the outside world.
Materials and Methods
Procedure I: Setting up PCR for 16S Amplification
1. Label 2 PCR tubes with the specific transect number, colony identifier, and group number.
2. Record the labeling system in a lab notebook.
3. Add 25 micro liters of primer/water mixture to a labeled PCR tube. Mix the two to dissolve the PCR bead.
4. Next, use a sterile toothpick to up a small amount of a bacterial colony that you wish to characterize.
5. Completely submerge the toothpick in the primer/water mix of a PCR tube and twist it for approximately 5 seconds. Throw out the toothpick in the correct container.
6. Cap the tube and place it into the PCR machine.
7. Repeat this process using a fresh toothpick.
8. Next lab period, you will run the PCR products onto an agarose gel.
Procedure II: Running the PCR products onto an agarose gel
1. Retrieve PCR products.
2. Pipette approximately 5 ul of the PCR product into the agarose gel.
3. Place agarose gel underneath the specific light and observe results.
Procedure III: Analyzing the PCR products on the agarose gel
1. You will be provided the 16S Nucleotide Sequence.
2. Access the following website: https://blast.ncbi.nlm.nih.gov/Blast.cgi?PAGE_TYPE=BlastSearch
3. Copy and past the sequence into the specified box called "Enter accession number(s), gi(s), or FASTA sequence(s)". Make sure to start/end the sequence 30 letters in. Hit "Blast."
4. After receiving the results, observe and make notes of the "Distribution of 100 Blast Hits on the Query Sequence."
5. Scroll down to "Sequences producing significant alignments"
6. Select the first description and record results.
Results:
Nucleotide Sequence CTTGCTGCTTCGCTGACGAGTGGCGGAC GGGTGAGTAATGTCTGGGAAACTGCCTGATGGAGGGGGATAACTACTGGAAACGGTAGCTAATACCGCATAACGTCGCAA GACCAAAGAGGGGGACCTTCGGGCCTCTTGCCATCAGATGTGCCCAGATGGGATTAGCTAGTAGGTGGGGTAACGGCTCA CCTAGGCGACGATCCCTAGCTGGTCTGAGAGGATGACCAGCCACACTGGAACTGAGACACGGTCCAGACTCCTACGGGAG GCAGCAGTGGGGAATATTGCACAATGGGCGCAAGCCTGATGCAGCCATGCCGCGTGTATGAAGAAGGCCTTCGGGTTGTA AAGTACTTTCAGCGGGGAGGAAGGCGATGTGGTTAATAACCACGTCGATTGACGTTACCCGCAGAAGAAGCACCGGCTAA CTCCGTGCCAGCAGCCGCGGTAATACGGAGGGTGCAAGCGTTAATCGGAATTACTGGGCGTAAAGCGCACGCAGGCGGTC TGTCAAGTCGGATGTGAAATCCCCGGGCTCAACCTGGGAACTGCATCCGAAACTGGCAGGCTTGAGTCTCGTAGAGGGGG GTAGAATTCCAGGTGTAGCGGTGAAATGCGTAGAGATCTGGAGGAATACCGGTGGCGAANGCGGCCCCCTGGACGAAGAC TGACGCTCANGTGCGAAAGCGTGGGGAGCAAACAGGATTAGATACCCTGGTAGTCCACGCCGTAAACGATGTCGACTTGG AGGTTGTGCCCTTGAGGCGTGGCTTCCGGAGCTAACGCGTTAAGTCGACCGCCTGGGGAGTACGGCCGCAANGTTAAAAC TCNNTGAATTGACGGGGGCCCGCACAAGCGGTGGAGCATGTGGTTTAATTCNATGCAACGCGAAGAACCTTACCTGGTCT TGACATCCACAGAACTT
Conclusion: It was found that the strain which we analyzed was a 99% match with Salmonella bongori SL18.
AP
Thursday, February 11, 2016
Characterizing Invertebrates Collected from Burlese Funnel
Purpose:
The purpose of this experiment was to collect samples from the Burlese Funnel Experiment in order to find and characterize the various kinds of invertebrates present in Transect 3. The hypothesis set for was that there would be a vast array of mostly arthropods. Based on the temperature fluctuations over the past weeks, it was assumed that there would be very few organisms to begin with, as most would have burrowed or died. We were able to identify organisms with the help of a dichotomous key and by looking at plates with the collected liquid under a microscope. We were only able to find 4 distinct organisms in the funnel, of which there actually more than one, showing that these organisms live together in a community as with bees.
Materials & Methods: Petri dishes, Berlese Funnel, Transfer pipettes, Dichotomous key, Microscope
1) Take a sample of alcohol from the Burlese funnel and look at under the microscope
2) Characterize vertebrates found using a dichotomous key
Table 1: Invertebrates Present in Burlese Funnel
Table 2: Vertebrates Present in Transect 3
Figure 1: Food Web Present in Transect 3
Conclusions:
The organisms found within Transect 3 range from the tiniest of microorganisms, to even us as humans. Each organism from the itty bitty Springtail to its sworn enemy the Ground Spider, fills a niche their environment. Each has his own place in the different trophic levels, only to be returned to the earth, aka the circle of life. The prey-predator relationships between these organisms is what define the particular transect as a microenvironment of the larger world. The balance that these prey-predator relationships as well as limited resources (over all natural selection) yield is paramount to the health and success of an environment.
AP
Thursday, February 4rd, 2016
Characterizing Plants and Fungi
Purpose:
The purpose of this experiment was to collect, characterize, and identify plants that were collected from Transect 3. The hypothesis set forth was that the plants we would find would either find monocots or dicots based on the vascularization of leaves and presence of single or double cotyledons as well as perhaps a few fungi samples. We did find a variety of different plants, from berries, leaves, and grass.
Materials and Methods:
Part 1: Ziplock bags, plant matter, dichotomous key, microscope
Part 2: Burlese funnel apparatus, ethanol, 50 mL conical tube
1. Go to Transect #3 with ziplock bags and retrieve foliage samples that will later be used for the Burlese Funnel
2. Take 5 samples of different plants, record characteristics, and identify plants using a dichotomous key and microscope
3. Begin by pouring 25 mL of the 50:50 ethanol/water solution into a 50 mL conical tube.
4. Fit a piece of screening material to the bottom of the funnel to prevent any leaf litter falling in
5. Empty contents of litter, and set up apparatus with funnel, tube, and ethanol
6) Leave for a week until next lab
Results:
The Fungi sporangia are the small, globelike structures that house the spores of the fungi are housed and are later dispersed from. They are important because without these, the fungi could not reproduce. We concluded that it was a zygomycete based on structure and coloration of the sporangia. [shown below]
Conclusions:
Transect 3 contained a variety of plants and fungi that are characteristic of warm temperate moist forest biome in which Washington, DC is located.
-AP
Thursday January 28th, 2016
Characterizing Colonies Using Gram Stain and Wet Mounts
Purpose:
The purpose of this experiment was to characterize the colonies and cells of bacterial species found in Transect 3 after having left the serially diluted agar plates to grow over the course of a week. We did so by observing the motility and behavior of the organisms using a wet mount that allowed to see the beings alive. We also employed the use of the Gram stain technique that allowed us to see whether the cell walls of the bacteria contained small or large amounts of peptidoglycan. It was hypothesized that the bacteria found on the regular agar plates/tet(-) would be far more abundant and diverse that the bacteria observed on the agar plates with tetracycline/tet(+), not to mention that the tet(-) would have some species that the tet(+). Tetracyclines inhibit bacterial protein synthesis by preventing the association of aminoacyl-tRNA with the bacterial ribosome and thus function as great antibiotics that have many applications. The fact that the plates treated with tetracycline had far fewer and diverse colonies indicates that those colonies we found were in fact antibiotic resistant. In general, tetracycline plates grew exponentially less than the regular ones. It would seem that there were approximately 2-3 species of bacteria that were resistant, while there were about 10 or so thriving on the tet(-).
Chopra,I. June 2001 "Tetracycline Antibiotics: Mode of Action, Applications, Molecular Biology, and Epidemiology of Bacterial Resistance". Journal of Microbiology and Molecular Biology Review. Volume 65(2).
The Hay Infusion Culture itself still smells rather horrible; however, it is not as acrid and revolting as it was the week prior. It also does not have as thick of a film on the surface and has gotten somewhat clear. This is possibly due to the presence of bacteria that have begun to break down and metabolize some of the other microorganisms in the culture.
Materials and Methods:
Characterizing Bacteria: glass slides and cover slips, bunsen burner, agar plates, microscope, Crystal Violet, Iodine, 95% Alcohol, Safranin Stain, distilled water, PCR tubes,
1) Retrieve the 8 agar plates from previous week and observe colony morphology and take samples from 2 of each (+) and (-) and place on glass slides.
2) Begin Gram stain process by evaporating excess water using a bunsen burner and continue with Gram stain protocol using Crystal Violet, Iodine, Alcohol, and then Safranin Stain, rinsing with deionized water between.
3) Let dry fully and observe bacteria under a microscope, recording whether or not the organisms are Gram positive or negative based off of the color of stained peptidoglycan.
4) Prepare a wet mounts of the same aforementioned samples from agar plates and observe behavior of bacterial species.
5) Take sample of bacteria, (-) and (+), and place in 2 PCR tubes for genetic analysis
1) coccus, Gram negative, wave-like motion; 2) bacillus, Gram positive, swimming sporadically; 3) bacillus, Gram negative, swimming sporadically; 4) coccus, Gram positive, wave-like motion (all at 40x magnification)
It was concluded that the same species of bacteria that were found on tet(+) were also found in larger numbers on the tet(-). This is not true for the inverse. Therefore, Transect 3 does in fact harbor antibiotic resistant bacteria.
AP
Thursday, January 21st, 2016
Taking a Microscopic Look at the Hay Infusion Culture
Purpose:
The purpose of this experiment was to identify the various kinds of organisms that grew on the top, middle, and bottom layers of the Hay Infusion Culture. In doing so, it is pertinent to notice how there are many different organisms that live in their own specific niches throughout the culture. It is expected that on the top layer, algae and other autotrophic organisms will reside because that is the best area to capture sunlight and photosynthesis, which would also mean there would also be some heterotrophs because the autotrophs provide a reliable food source. Within the culture in the middle and bottom layers, it is expected that we would find autotrophic organisms.
Materials and Methods:
Part 1: Hay Infusion Culture, microscope, glass slides and cover slips, transfer pipettes, and a dichotomous key in order to identify organisms
Part 2: 8 agar plates, P100 pipette and tips, samples from hay infusion, nutrient broth, 4 test tubes, test tube rack, glass spreader, bunsen burner
1. Observe the Hay Infusion Culture and note physical characteristics
2. Identify the different layers of the Hay Infusion Culture
3. Observe a sample from each niche using transfer pipettes, a microscope, and slides
4. Identify and measure each organism found using a dichotomous key.
5. Collect and label four tubes of 10mLs sterile broth with 10^-2, 10^-4,10^-6,10^-8 and four nutrient agar and four nutrient agar plus tetracycline plates. Label the plates with tetracycline with "tet" - and name one of each with 10^-3, 10^-5, 1^-7, and 10^-9
6. Add 100 micro Liters from the culture to the 10mLs of broth in the tube labeled 10^-2, swirl and pipette 100 micro liters of that to each 10^-3 plate.
7.Take 100 micro liters from tube 10^-2, put in 10^4, and repeat until you complete each agar plate with the serial dilutions.
8. Set the agar plates aside onto a rack. Leave them there at room temperature for a week.
The Hay Infusion Culture is exceptionally revolting, exuding the acrid scent of mold tinged with excrement akin to a sewer, resulting in a pungent mustiness that mildly stings the nose and brings tears of disgust to the eyes. It is very dark and murky, especially near the surface and looks very much like sewage. On the surface of the culture there is quite a bit of mold, forming a dense and sticky film that does not break very easily.
The organisms, from for example the surface versus those submerged, may differ because said organisms require certain environments in their niches to thrive. Some of the organisms on the surface may require direct oxygen from the air to survive, while those under the water prefer the more stable living conditions that water provides. The organisms living near plant life most likely do so because the decomposing plant matter provides them with last sustenance.
Most of the organisms observed were extremely motile, zipping along as if they had not a care in the world. The organisms were both protozoan and algal. It is most likely that those near the surface and with green coloration were in fact photosynthetic.
Types of Organisms found:
Raw Data: Top Layer Gonium, Pandorina, Colpidium (50-70µm)
Middle Layer Volvox (350-500µm), Paramecium bursaria (70-110µm), Spirostomum (1-3mm), Euglena (35-55µm)
Bottom Layer Blepharisma (400-600µm), Didinium cyst, Chilomonas (20-40µm), Spirostomum (1-3mm), Pandorina (20-250µm)
From left to right: Euglena, Spirostomum, Didium Cyst, Volvox, Eudorina, Colpidium
The Blepharisma can be categorized as a living organism because it possesses the five fundamental characteristics of all living things. They acquire energy by consuming other organisms such as bacteria and other ciliates by engulfing the organism and digesting it. It is a membrane-bound unicellular organism. It exchanges information between itself and the environment as well as passes its genes on after reproduction which is carried out by binary fission. These organisms have evolved from an ancestral unicellular organism that we also share.
If the Hay Infusion Culture “grew” for another two months what changes would you predict to occur? What selective pressures would affect the community of your samples? If the culture were allowed to grow for another two months, it is likely that the protozoans would consume many of the algal organisms leaving mostly protozoans. There would also be quite a bit more mold in the culture. The culture as a whole would likely be over run with all kinds of organisms due to the plethora of nutrients available and reproduction. Over a longer period of time, however, many of the organisms would probably die due to intense saturation and an inevitable decrease in oxygen levels.
Serial Dilution:
Conclusions:
It was observed that there were many different kinds of organisms with great diversity between the Top, Middle, and Bottom layers. This is indicative of the fact that certain organisms tend to thrive in their own specific niches.
-AP
Thursday, January 14th, 2016
TRANSECT 3
The location of this particular transect is called the Butler Pavilion and is in the middle of Battelle-Tompkins Memorial Building, Hughes Hall, McDowell Hall, Woods-Brown Amphitheater, Mary Graydon Center, and Bender Arena. The topography of this location includes a multitude of different plant life such as flowers, bushes, and trees planted in a clay-like soil covered in a dark black mulch. There is a winding path of concrete that snakes through this garden-like place.
-AP